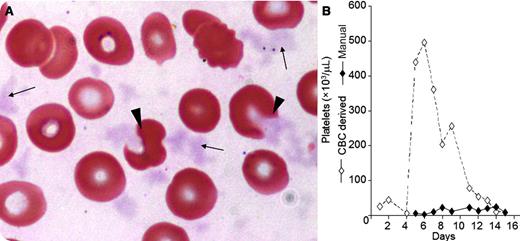
A 71-year-old patient with mantle cell lymphoma was treated in the setting of a randomized clinical trial protocol in which he received the combination of bendamustine and rituximab, with the addition of either ibrutinib or placebo. Four weeks after the first cycle, the patient developed severe pancytopenia. Bone marrow biopsy revealed a marrow devoid of hematopoietic cells, but with significant infiltration by lymphoma cells. Three days later, complete blood count showed a rapid apparent improvement in platelet counts, reaching 496 × 109/L within 6 days (panel B), while concurrent manual platelet count disclosed severe thrombocytopenia. The thrombocytopenia was accompanied by precipitates scattered throughout the film, occasionally attached to red blood cells (panel A, arrows). Some of these precipitates altered the erythrocyte morphology in a manner that can be misinterpreted as cell fragments (panel A, arrowheads). These findings suggested the presence of cryoglobulins that were indeed detected. Protein electrophoresis and immunofixation revealed an immunoglobulin M paraprotein. / Cryoglobulins are immunoglobulins that precipitate at temperatures below 37°C, producing high–molecular-weight aggregates. The precipitated cryoglobulin particles of various sizes may falsely be recognized as leukocytes or platelets causing pseudoleukocytosis and pseudothrombocytosis, respectively. In this patient, pseudothrombocytosis occurred, with the leukocyte counts being valid (0.4-3.6 × 109/L) throughout the event.

A 71-year-old patient with mantle cell lymphoma was treated in the setting of a randomized clinical trial protocol in which he received the combination of bendamustine and rituximab, with the addition of either ibrutinib or placebo. Four weeks after the first cycle, the patient developed severe pancytopenia. Bone marrow biopsy revealed a marrow devoid of hematopoietic cells, but with significant infiltration by lymphoma cells. Three days later, complete blood count showed a rapid apparent improvement in platelet counts, reaching 496 × 109/L within 6 days (panel B), while concurrent manual platelet count disclosed severe thrombocytopenia. The thrombocytopenia was accompanied by precipitates scattered throughout the film, occasionally attached to red blood cells (panel A, arrows). Some of these precipitates altered the erythrocyte morphology in a manner that can be misinterpreted as cell fragments (panel A, arrowheads). These findings suggested the presence of cryoglobulins that were indeed detected. Protein electrophoresis and immunofixation revealed an immunoglobulin M paraprotein.
Cryoglobulins are immunoglobulins that precipitate at temperatures below 37°C, producing high–molecular-weight aggregates. The precipitated cryoglobulin particles of various sizes may falsely be recognized as leukocytes or platelets causing pseudoleukocytosis and pseudothrombocytosis, respectively. In this patient, pseudothrombocytosis occurred, with the leukocyte counts being valid (0.4-3.6 × 109/L) throughout the event.
A 71-year-old patient with mantle cell lymphoma was treated in the setting of a randomized clinical trial protocol in which he received the combination of bendamustine and rituximab, with the addition of either ibrutinib or placebo. Four weeks after the first cycle, the patient developed severe pancytopenia. Bone marrow biopsy revealed a marrow devoid of hematopoietic cells, but with significant infiltration by lymphoma cells. Three days later, complete blood count showed a rapid apparent improvement in platelet counts, reaching 496 × 109/L within 6 days (panel B), while concurrent manual platelet count disclosed severe thrombocytopenia. The thrombocytopenia was accompanied by precipitates scattered throughout the film, occasionally attached to red blood cells (panel A, arrows). Some of these precipitates altered the erythrocyte morphology in a manner that can be misinterpreted as cell fragments (panel A, arrowheads). These findings suggested the presence of cryoglobulins that were indeed detected. Protein electrophoresis and immunofixation revealed an immunoglobulin M paraprotein.
Cryoglobulins are immunoglobulins that precipitate at temperatures below 37°C, producing high–molecular-weight aggregates. The precipitated cryoglobulin particles of various sizes may falsely be recognized as leukocytes or platelets causing pseudoleukocytosis and pseudothrombocytosis, respectively. In this patient, pseudothrombocytosis occurred, with the leukocyte counts being valid (0.4-3.6 × 109/L) throughout the event.
For additional images, visit the ASH IMAGE BANK, a reference and teaching tool that is continually updated with new atlas and case study images. For more information visit http://imagebank.hematology.org.

This feature is available to Subscribers Only
Sign In or Create an Account Close Modal